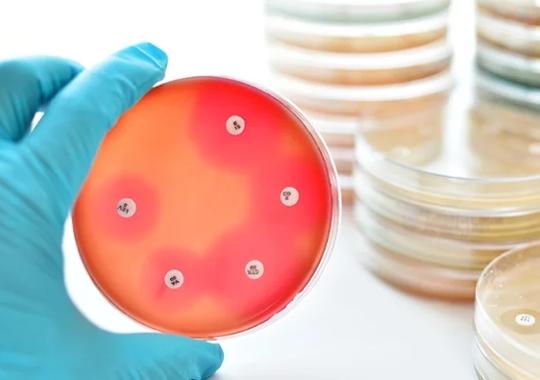
Join Us in Raising Awareness about Antimicrobial Stewardship

Rapid molecular diagnostics make a difference for both antimicrobial resistance and C. difficile
It’s World Antimicrobial Awareness Week! A global campaign from the World Health Organization occurring November 18-24 is dedicated to raising awareness about the growing threat of antimicrobial resistance.
This challenge is no surprise to the life science community, where scientists and clinicians alike have been battling the effects of increasing pathogen resistance to our go-to therapies. Antibiotics in particular are increasingly ineffective; doctors around the world are now regularly reporting bacterial strains that are resistant to all known classes of treatment.
Antimicrobial resistance threatens to erase decades of medical progress
Returning us to the days when bacterial infections were often fatal, researchers have estimated that antibiotic resistance was responsible for nearly 1.3 million deaths in 2019 alone.
Fortunately, there is cause for hope. In a report published in 2019, the US Centers for Disease Control and Prevention found that antimicrobial stewardship programs have been successful over time, making a noticeable dent in the spread of antimicrobial resistance. Unfortunately, the COVID-19 pandemic and mass use of antibiotics for hospitalized patients appears to have reversed much of that progress. Still, the stewardship model has proven effective. Rolling out similar programs around the world could make a real difference in slowing the spread of drug-resistant pathogens.
One of the most important pillars of antimicrobial stewardship is the use of rapid molecular diagnostic tests that provide actionable information about a pathogen’s drug-resistance profile. Generating these results quickly makes it possible to de-escalate patients from broad-spectrum antibiotics to more targeted treatments that are less likely to cause resistance.
We are proud to offer tests that are contributing to the fight against antimicrobial resistance
Clinical laboratories often use our VERIGENE® Bloodstream Infection assay portfolio to identify specific pathogens and their resistance profile in order to guide treatment selection. These assays generate results directly from positive blood culture bottles and produce actionable results in just three hours, slashing more than 30 hours from the traditional culture-based testing workflow and allowing doctors to adjust antibiotic use in a clinically relevant time frame.
Finding effective and responsible ways to avoid the long-term use of broad-spectrum antibiotics is also essential for reducing incidents of hospital-acquired infections. One notably common hospital-acquired infection is that caused by Clostridioides difficile (C. diff), which generates severe gastrointestinal distress. Overuse of heavy-duty antibiotics is one of the primary causes of C. diff spread; the infection is often acquired when patients’ healthy microbiomes have been wiped out, leaving them vulnerable to such pathogens.
While C. diff infection can be dangerous and potentially life-threatening, it is not well known in the general public. That’s why November is C. diff Awareness Month, a designation implemented several years ago by the CDC in an effort to help people better understand C. diff infection and how to prevent it.
Because C. diff infections can pose major consequences for patients, rapid detection and treatment are highly important. We have developed both the ARIES® C. difficile Assay, an in-vitro diagnostic that produces results in just two hours, and the Simplexa® C. difficile Direct kit, which is designed for moderate-complexity CLIA labs and generates results in about an hour.
The Diasorin team is committed to helping in the fight against antimicrobial resistance and related hospital-acquired infections such as C. diff. We encourage you to participate in awareness-raising efforts to promote better health for all.
Check out these resources to learn more:
- Global events planned for World Antimicrobial Awareness Week
- Get involved in antimicrobial awareness through the CDC
- Diagnosis and Management of Bloodstream Infections With Rapid, Multiplexed Molecular Assays
- MLO Magazine: Rapid diagnostics improve care for bloodstream infections
- Clinical practice guidelines for diagnosing and treating C. diff